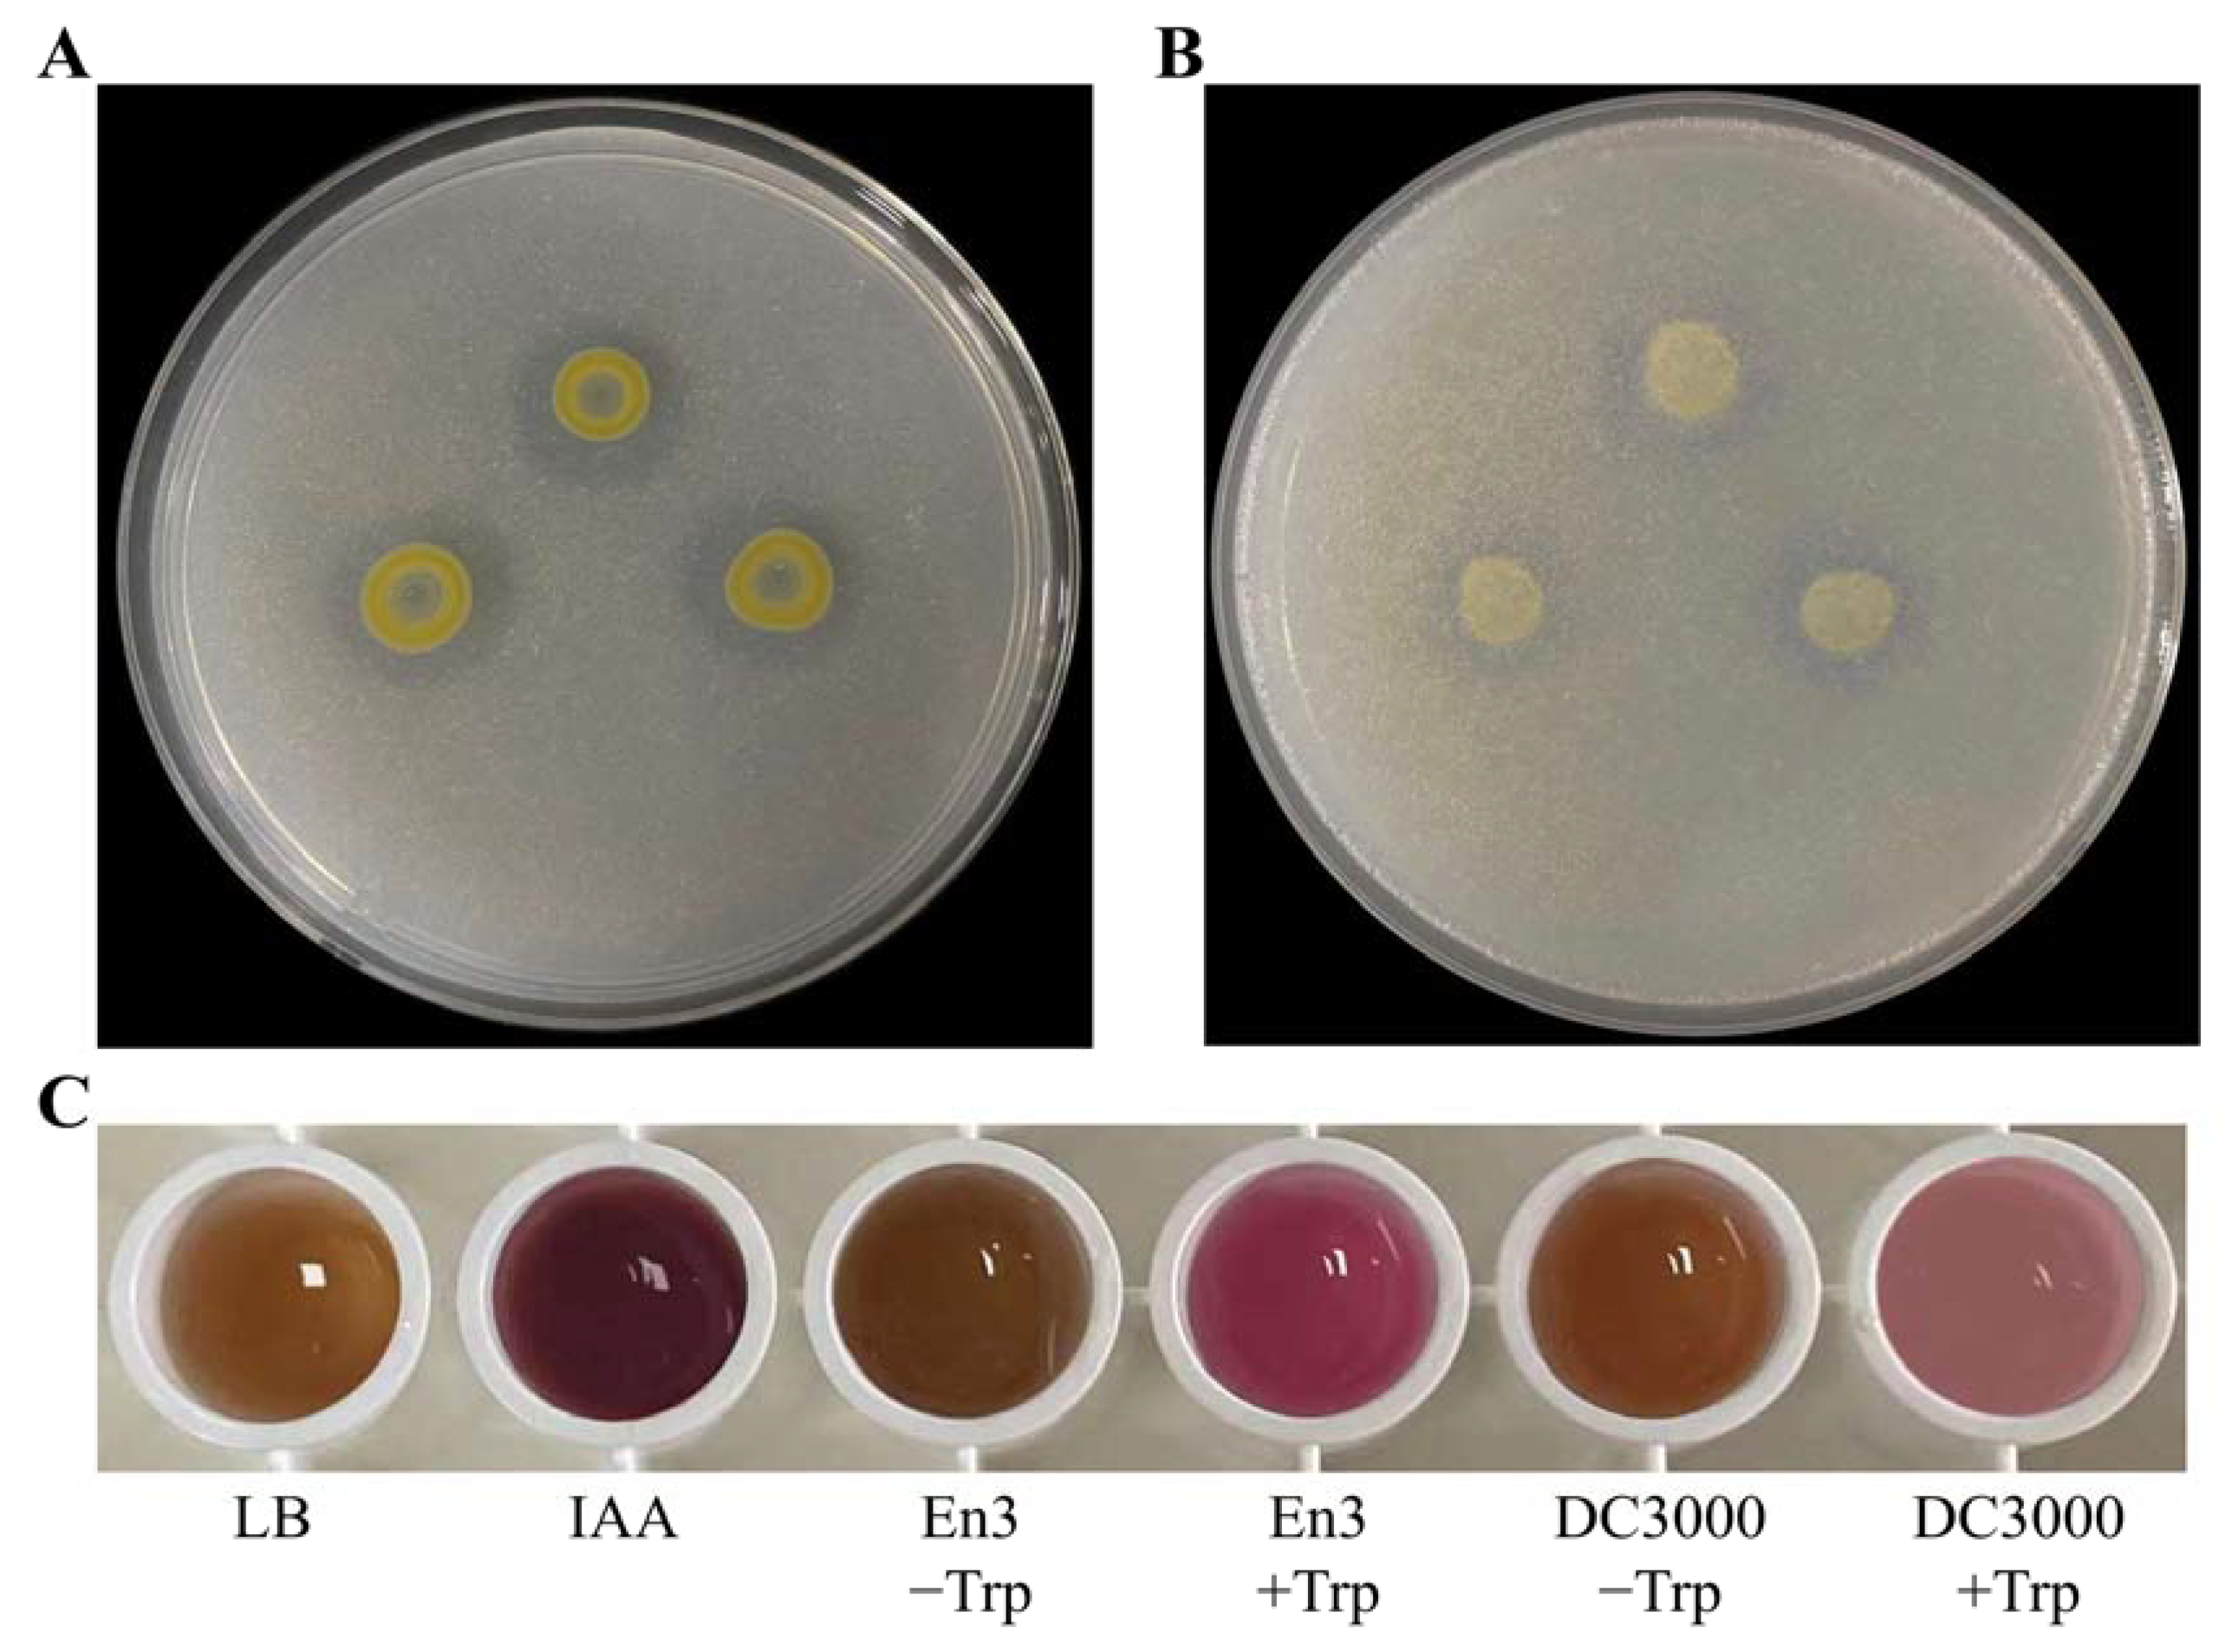
Forests 14 02203 g002

Characterization of Pseudomonas sp. En3, an Endophytic Bacterium from Poplar Leaf Endosphere with Plant Growth-Promoting Properties
Abstract
:1. Introduction
2. Materials and Methods
2.1. Isolation of Endophytic Bacteria from Poplar Leaves
2.2. Identification of Endophytic Bacteria
2.3. Plant Growth-Promoting Assays
2.4. Plant Growth-Promoting Properties of Strain En3
2.5. Analysis of the Colonization of Strain En3 in Multiple Plants
2.6. Genome Sequencing, Assembling, and Annotation
2.7. Phylogenetic and Average Nucleotide Identity (ANI) Analyses
3. Results
3.1. Isolation of Endophytic Bacteria from Poplar Leaves and Analysis of Plant Growth-Promoting Activity
3.2. Analysis of PGP Features of Pseudomonas sp. En3
3.3. Analyzing Colonization Activity of Pseudomonas sp. En3
3.4. General Features of the Pseudomonas sp. En3 Genome
3.5. Phylogenetic Analysis
3.6. Plant Growth-Promoting and Colonization Features of the Pseudomonas sp. En3 Genome
4. Discussion
5. Conclusions
Supplementary Materials
Author Contributions
Funding
Data Availability Statement
Conflicts of Interest
References
- Bacon, C.W.; Hinton, D.M. Bacterial endophytes: The endophytic niche, its occupants, and its utility. In Plant-Associated Bacteria; Gnanamanickam, S.S., Ed.; Springer: Dordrecht, The Netherlands, 2006; pp. 155–194. [Google Scholar]
- Morales-Cedeño, L.R.; del Carmen Orozco-Mosqueda, M.; Loeza-Lara, P.D.; Parra-Cota, F.I.; de los Santos-Villalobos, S.; Santoyo, G. Plant growth-promoting bacterial endophytes as biocontrol agents of pre- and post-harvest diseases: Fundamentals, methods of application and future perspectives. Microbiol. Res. 2021, 242, 126612. [Google Scholar] [CrossRef] [PubMed]
- Santoyo, G.; Moreno-Hagelsieb, G.; del Carmen Orozco-Mosqueda, M.; Glick, B.R. Plant growth-promoting bacterial endophytes. Microbiol. Res. 2016, 183, 92–99. [Google Scholar] [CrossRef] [PubMed]
- Lalucat, J.; Mulet, M.; Gomila, M.; García-Valdés, E. Genomics in Bacterial Taxonomy: Impact on the Genus Pseudomonas. Genes 2020, 11, 139. [Google Scholar] [CrossRef] [PubMed]
- Yan, Y.L.; Yang, J.; Dou, Y.T.; Chen, M.; Ping, S.Z.; Peng, J.P.; Lu, W.; Zhang, W.; Yao, Z.Y.; Li, H.Q.; et al. Nitrogen fixation island and rhizosphere competence traits in the genome of root-associated Pseudomonas stutzeri A1501. Proc. Natl. Acad. Sci. USA 2008, 105, 7564–7569. [Google Scholar] [CrossRef]
- Oteino, N.; Lally, R.D.; Kiwanuka, S.; Lloyd, A.; Ryan, D.; Germaine, K.J.; Dowling, D.N. Plant growth promotion induced by phosphate solubilizing endophytic Pseudomonas isolates. Front. Microbiol. 2015, 6, 745. [Google Scholar] [CrossRef]
- Emami, S.; Alikhani, H.A.; Pourbabaei, A.A.; Etesami, H.; Sarmadian, F.; Motessharezadeh, B. Assessment of the Potential of Indole-3-Acetic Acid Producing Bacteria to manage Chemical Fertilizers Application. Int. J. Environ. Res. Public Health 2019, 13, 603–611. [Google Scholar] [CrossRef]
- Weyens, N.; Boulet, J.; Adriaensen, D.; Timmermans, J.P.; Prinsen, E.; Van Oevelen, S.; D’Haen, J.; Smeets, K.; van der Lelie, D.; Taghavi, S.; et al. Contrasting colonization and plant growth promoting capacity between wild type and a gfp-derative of the endophyte Pseudomonas putida W619 in hybrid poplar. Plant Soil. 2012, 356, 217–230. [Google Scholar] [CrossRef]
- Ali, S.; Charles, T.C.; Glick, B.R. Delay of flower senescence by bacterial endophytes expressing 1-aminocyclopropane-1-carboxylate deaminase. J. Appl. Microbiol. 2012, 113, 1139–1144. [Google Scholar] [CrossRef]
- Chlebek, D.; Pinski, A.; Zur, J.; Michalska, J.; Hupert-Kocurek, K. Genome Mining and Evaluation of the Biocontrol Potential of Pseudomonas fluorescens BRZ63, a New Endophyte of Oilseed Rape (Brassica napus L.) against Fungal Pathogens. Int. J. Mol. Sci 2020, 21, 8740. [Google Scholar] [CrossRef]
- Montes-Osuna, N.; Cernava, T.; Gomez-Lama Cabanas, C.; Berg, G.; Mercado-Blanco, J. Identification of Volatile Organic Compounds Emitted by Two Beneficial Endophytic Pseudomonas Strains from Olive Roots. Plants 2022, 11, 318. [Google Scholar] [CrossRef]
- Agisha, V.N.; Kumar, A.; Eapen, S.J.; Sheoran, N.; Suseelabhai, R. Broad-spectrum antimicrobial activity of volatile organic compounds from endophytic Pseudomonas putida BP25 against diverse plant pathogens. Biocontrol. Sci. Technol. 2019, 29, 1069–1089. [Google Scholar] [CrossRef]
- Kong, Z.Y.; Deng, Z.S.; Glick, B.R.; Wei, G.H.; Chou, M.X. A nodule endophytic plant growth-promoting Pseudomonas and its effects on growth, nodulation and metal uptake in Medicago lupulina under copper stress. Ann. Microbiol. 2017, 67, 49–58. [Google Scholar] [CrossRef]
- Chen, B.; Luo, S.; Wu, Y.J.; Ye, J.Y.; Wang, Q.; Xu, X.M.; Pan, F.S.; Khan, K.Y.; Feng, Y.; Yang, X. The effects of the endophytic bacterium Pseudomonas fluorescens Sasm05 and IAA on the plant growth and cadmium uptake of Sedum alfredii Hance. Front. Microbiol. 2017, 8, 2538. [Google Scholar] [CrossRef]
- Ma, Y.; Rajkumar, M.; Moreno, A.; Zhang, C.; Freitas, H. Serpentine endophytic bacterium Pseudomonas azotoformans ASS1 accelerates phytoremediation of soil metals under drought stress. Chemosphere 2017, 185, 75–85. [Google Scholar] [CrossRef] [PubMed]
- Bradshaw, H.; Ceulemans, R.; Davis, J.; Stettler, R. Emerging model systems in plant biology: Poplar (Populus) as a model forest tree. J. Plant Growth Regul. 2000, 19, 306–313. [Google Scholar] [CrossRef]
- Xin, G.; Zhang, G.Y.; Kang, J.W.; Staley, J.T.; Doty, S.L. A diazotrophic, indole-3-acetic acid-producing endophyte from wild cottonwood. Biol. Fertil. Soils 2009, 45, 669–674. [Google Scholar] [CrossRef]
- Ren, J.H.; Ye, J.R.; Liu, H.; Xu, X.L.; Wu, X.Q. Isolation and characterization of a new Burkholderia pyrrocinia strain JK-SH007 as a potential biocontrol agent. World J. Microbiol. Biotechnol. 2011, 27, 2203–2215. [Google Scholar] [CrossRef]
- Liu, W.H.; Chen, F.F.; Wang, C.E.; Fu, H.H.; Fang, X.Q.; Ye, J.R.; Shi, J.Y. Indole-3-Acetic Acid in Burkholderia pyrrocinia JK-SH007: Enzymatic Identification of the Indole-3-Acetamide Synthesis Pathway. Front. Microbiol. 2019, 10, 2559. [Google Scholar] [CrossRef]
- Taghavi, S.; Garafola, C.; Monchy, S.; Newman, L.; Hoffman, A.; Weyens, N.; Barac, T.; Vangronsveld, J.; van der Lelie, D. Genome survey and characterization of endophytic bacteria exhibiting a beneficial effect on growth and development of poplar trees. Appl. Environ. Microbiol. 2009, 75, 748–757. [Google Scholar] [CrossRef]
- Prodhan, M.Y.; Rahman, M.B.; Rahman, A.; Akbor, M.A.; Ghosh, S.; Nahar, M.N.E.; Simo; Shamsuzzoha, M.; Cho, K.M.; Haque, M.A. Characterization of Growth-Promoting Activities of Consortia of Chlorpyrifos Mineralizing Endophytic Bacteria Naturally Harboring in Rice Plants—A Potential Bio-Stimulant to Develop a Safe and Sustainable Agriculture. Microorganisms 2023, 11, 1821. [Google Scholar] [CrossRef]
- Nautiyal, C.S. An efficient microbiological growth medium for screening phosphate solubilizing microorganisms. FEMS Microbiol. Lett. 1999, 170, 265–270. [Google Scholar] [CrossRef] [PubMed]
- Kizilkaya, R. Yield response and nitrogen concentrations of spring wheat (Triticum aestivum) inoculated with Azotobacter Chroococcum strains. Ecol. Eng. 2008, 33, 150–156. [Google Scholar] [CrossRef]
- Bric, J.M.; Bostock, R.M.; Silverstone, S.E. Rapid in situ assay for indoleacetic acid production by bacteria immobilized on a nitrocellulose membrane. Appl. Environ. Microbiol. 1991, 57, 535–538. [Google Scholar] [CrossRef] [PubMed]
- Sun, K.; Liu, J.; Gao, Y.Z.; Sheng, Y.H.; Kang, F.X.; Waigi, M.G. Inoculating plants with the endophytic bacterium Pseudomonas sp. Ph6-gfp to reduce phenanthrene contamination. Environ. Sci. Pollut. Res. 2015, 22, 19529–19537. [Google Scholar] [CrossRef]
- Wick, R.R.; Judd, L.M.; Gorrie, C.L.; Holt, K.E. Unicycler: Resolving bacterial genome assemblies from short and long sequencing reads. PLoS Comput. Biol. 2017, 13, e1005595. [Google Scholar] [CrossRef]
- Walker, B.J.; Abeel, T.; Shea, T.; Priest, M.; Abouelliel, A.; Sakthikumar, S.; Cuomo, C.A.; Zeng, Q.D.; Wortman, J.; Earl, A.M.; et al. Pilon: An integrated tool for comprehensive microbial variant detection and genome assembly improvement. PLoS ONE 2014, 9, e112963. [Google Scholar] [CrossRef]
- Seemann, T. Prokka: Rapid prokaryotic genome annotation. Bioinformatics 2014, 30, 2068–2069. [Google Scholar] [CrossRef]
- Lalucat, J.; Gomila, M.; Mulet, M.; Zaruma, A.; Garcia-Valdes, E. Past, present and future of the boundaries of the Pseudomonas genus: Proposal of Stutzerimonas gen. Nov. Syst. Appl. Microbiol. 2022, 45, 126289. [Google Scholar] [CrossRef]
- Kumar, S.; Stecher, G.; Tamura, K. MEGA7: Molecular Evolutionary Genetics Analysis Version 7.0 for Bigger Datasets. Mol. Biol. Evol. 2016, 33, 1870–1874. [Google Scholar] [CrossRef]
- Yoon, S.H.; Ha, S.M.; Lim, J.M.; Kwon, S.J.; Chun, J. A large-scale evaluation of algorithms to calculate average nucleotide identity. Antonie Van Leeuwenhoek 2017, 110, 1281–1286. [Google Scholar] [CrossRef]
- Alanjary, M.; Steinke, K.; Ziemert, N. AutoMLST: An automated web server for generating multi-locus species trees highlighting natural product potential. Nucleic. Acids. Res. 2019, 47, W276–W282. [Google Scholar] [CrossRef] [PubMed]
- Richter, M.; Rosselló-Móra, R. Shifting the genomic gold standard for the prokaryotic species definition. Proc. Natl. Acad. Sci. USA 2009, 106, 19126–19131. [Google Scholar] [CrossRef] [PubMed]
- Peix, A.; Ramírez-Bahena, M.H.; Velázquez, E. Historical evolution and current status of the taxonomy of genus Pseudomonas. Infect. Genet. Evol. 2009, 9, 1132–1147. [Google Scholar] [CrossRef] [PubMed]
- Mende, D.R.; Sunagawa, S.C.; Zeller, G.; Bork, P. Accurate and universal delineation of prokaryotic species. Nat. Methods 2013, 10, 881–884. [Google Scholar] [CrossRef]
- Glaeser, S.P.; Kämpfer, P. Multilocus sequence analysis (MLSA) in prokaryotic taxonomy. Syst. Appl. Microbiol. 2015, 38, 237–245. [Google Scholar] [CrossRef]
- Goris, J.; Konstantinidis, K.T.; Klappenbach, J.A.; Coenye, T.; Vandamme, P.; Tiedje, J.M. DNA-DNA hybridization values and their relationship to whole-genome sequence similarities. Int. J. Syst. Evol. Microbiol. 2007, 57, 81–91. [Google Scholar] [CrossRef]
- Girard, L.; Lood, C.; Höfte, M.; Vandamme, P.; Rokni-Zadeh, H.; van Noort, V.; Lavigne, R.; De Mot, R. The Ever-Expanding Pseudomonas Genus: Description of 43 New Species and Partition of the Pseudomonas putida Group. Microorganisms 2021, 9, 1766. [Google Scholar] [CrossRef]
- Peix, A.; Rivas, R.; Mateos, P.F.; Martínez-Molina, E.; Rodríguez-Barrueco, C.; Velázquez, E. Pseudomonas rhizosphaerae sp nov., a novel species that actively solubilizes phosphate in vitro. Int. J. Syst. Evol. Microbiol. 2003, 53, 2067–2072. [Google Scholar] [CrossRef]
- Menéndez, E.; Ramírez-Bahena, M.H.; Fabryová, A.; Igual, J.M.; Benada, O.; Mateos, P.F.; Peix, A.; Kolařík, M.; García-Fraile, P. Pseudomonas coleopterorum sp nov., a cellulase-producing bacterium isolated from the bark beetle Hylesinus fraxini. Int. J. Syst. Evol. Microbiol. 2015, 65, 2852–2858. [Google Scholar] [CrossRef]
- Malhotra, H.; Vandana; Sharma, S.; Pandey, R. Phosphorus nutrition: Plant growth in response to deficiency and excess. In Plant Nutrients and Abiotic Stress Tolerance; Hasanuzzaman, M., Fujita, M., Oku, H., Nahar, K., Hawrylak-Nowak, B., Eds.; Springer Nature Ltd.: Singapore, 2018; pp. 171–190. [Google Scholar]
- Zeng, Q.W.; Wu, X.Q.; Wen, X.Y. Identification and characterization of the rhizosphere phosphate-solubilizing bacterium Pseudomonas frederiksbergensis JW-SD2, and its plant growth-promoting effects on poplar seedlings. Ann. Microbiol. 2016, 66, 1343–1354. [Google Scholar] [CrossRef]
- Batista, M.B.; Dixon, R. Manipulating nitrogen regulation in diazotrophic bacteria for agronomic benefit. Biochem. Soc. Trans. 2019, 47, 603–614. [Google Scholar] [CrossRef] [PubMed]
- Li, H.B.; Singh, R.K.; Singh, P.; Song, Q.Q.; Xing, Y.X.; Yang, L.T.; Li, Y.R. Genetic diversity of nitrogen-fixing and plant growth promoting Pseudomonas species isolated from sugarcane rhizosphere. Front. Microbiol. 2017, 8, 1268. [Google Scholar] [CrossRef] [PubMed]
- Fox, A.R.; Soto, G.; Valverde, C.; Russo, D.; Lagares, A., Jr.; Zorreguieta, Á.; Alleva, K.; Pascuan, C.; Frare, R.; Ayub, N.D. Major cereal crops benefit from biological nitrogen fixation when inoculated with the nitrogen—Fixing bacterium Pseudomonas protegens Pf—5 X940. Environ. Microbiol. 2016, 18, 3522–3534. [Google Scholar] [CrossRef] [PubMed]
- Ke, X.B.; Feng, S.; Wang, J.; Lu, W.; Zhang, W.; Chen, M.; Lin, M. Effect of inoculation with nitrogen-fixing bacterium Pseudomonas stutzeri A1501 on maize plant growth and the microbiome indigenous to the rhizosphere. Syst. Appl. Microbiol. 2019, 42, 248–260. [Google Scholar] [CrossRef]
- Johnson, D.C.; Dos Santos, P.C.; Dean, D.R. NifU and NifS are required for the maturation of nitrogenase and cannot replace the function of isc-gene products in Azotobacter vinelandii. Biochem. Soc. Trans. 2005, 33, 90–93. [Google Scholar] [CrossRef]
- Reitzer, L. Nitrogen assimilation and global regulation in Escherichia coli. Annu. Rev. Microbiol. 2003, 57, 155–176. [Google Scholar] [CrossRef]
- Patten, C.L.; Glick, B.R. Role of Pseudomonas putida indoleacetic acid in development of the host plant root system. Appl. Environ. Microbiol. 2002, 68, 3795–3801. [Google Scholar] [CrossRef]
- Gupta, R.; Anand, G.; Bar, M. Developmental Phytohormones: Key Players in Host-Microbe Interactions. J. Plant Growth Regul. 2023, 42, 1–22. [Google Scholar] [CrossRef]
- McClerklin, S.A.; Lee, S.G.; Harper, C.P.; Nwumeh, R.; Jez, J.M.; Kunkel, B.N. Indole-3-acetaldehyde dehydrogenase-dependent auxin synthesis contributes to virulence of Pseudomonas syringae strain DC3000. PLoS Pathog. 2018, 14, e1006811. [Google Scholar] [CrossRef]
- Gao, Y.B.; Dai, X.H.; Aoi, Y.K.; Takebayashi, Y.; Yang, L.P.; Guo, X.R.; Zeng, Q.W.; Yu, H.C.Z.; Kasahara, H.; Zhao, Y.D. Two homologous INDOLE-3-ACETAMIDE (IAM) HYDROLASE genes are required for the auxin effects of IAM in Arabidopsis. J. Genet. Genom. 2020, 47, 157–165. [Google Scholar] [CrossRef]
- Bernal, P.; Llamas, M.A.; Filloux, A. Type VI secretion systems in plant—Associated bacteria. Environ. Microbiol. 2018, 20, 1–15. [Google Scholar] [CrossRef] [PubMed]

| Endophyte | Top Hit (Accession No.) | Sequence Length (bp) | % Identity | Genbank Accession No. |
|---|---|---|---|---|
| En1 | Sphingomonas sanguinis NBRC 13937T (NR_113637) | 1409 | 99.86 | OR511661 |
| En2 | Sphingobium yanoikuyae NBRC 15102T (NR_113730) | 1409 | 99.72 | OR511660 |
| En3 | Pseudomonas azerbaijanorientalis SWRI123T (CP077078) | 1448 | 99.10 | OR511655 |
| En4 | Microbacterium testaceum NBRC 12675T (NZ_BJMLO1000022) | 1444 | 99.10 | OR511666 |
| Indole Derivatives | IAA | IAM | IPyA | IAN |
|---|---|---|---|---|
| Mass-to-charge ratio (M/Z) | 176.2 ≥ 129.8 | 175.0 ≥ 130.0 | 202.0 ≥ 114.9 | 157.1 ≥ 130.0 |
| Acqusion Standard | 5.49 | 4.74 | 6.10 | 6.35 |
| time(min) Sample | 5.50 | 4.74 | 6.10 | 6.35 |
| Concentration (ng/mL) a | 7.947 ± 0.342 | 1137.607 ± 21.849 | 1487.677 ± 37.020 | 14.100 ± 0.420 |
| Indole Derivatives | IAA | IAM | IPyA | IAN |
|---|---|---|---|---|
| Mass-to-charge ratio (M/Z) | 176.2 ≥ 129.8 | 175.0 ≥ 130.0 | 202.0 ≥ 114.9 | 157.1 ≥ 130.0 |
| Acqusion Standard | 5.49 | 4.74 | 6.10 | 6.35 |
| time(min) Sample | 5.51 | 4.74 | 6.10 | 6.35 |
| Concentration (ng/mL) a | 2.787 ± 0.214 | 125.743 ± 6.579 | 198.283 ± 12.689 | 1.600 ± 0.249 |
| Feature | Value |
|---|---|
| Genome size (bp) | 5,350,973 |
| Contig | 1 |
| GC content (%) | 60.45 |
| tRNA | 67 |
| rRNA (5S, 16S, 23S) | 16 (6,5,5) |
| Protein-coding genes (CDS) | 4807 |
| Average CDS length (nt) | 1003 |
| CDS assigned to NR | 4729 |
| CDS assigned to KEGG | 1746 |
| Secreted protein | 501 |
| PGP Activity | Gene | Gene Annotation | Locus |
|---|---|---|---|
| Nitrogen Metabolism | iscU | nitrogen fixation protein NifU and related proteins | ctg_01045 |
| iscS | cysteine desulfurase | ctg_01044 | |
| NRT | MFS transporter, nitrate/nitrite transporter | ctg_02133 | |
| gltB | glutamate synthase (NADPH) large chain | ctg_00450 | |
| gltD | glutamate synthase (NADPH) small chain | ctg_00451 | |
| nirB | nitrite reductase (NADH) large subunit | ctg_01700 | |
| nirD | nitrite reductase (NADH) small subunit | ctg_01701 | |
| norR | anaerobic nitric oxide reductase transcription regulator | ctg_01006 | |
| hmp | nitric oxide dioxygenase | ctg_01007 | |
| Phosphate Metabolism | phoB | OmpR family, phosphate regulon response regulator | ctg_00055 |
| phoR | OmpR family, phosphate regulon sensor kinase | ctg_00056 | |
| phoU | phosphate transport system protein | ctg_00061 | |
| pstB | phosphate transport system ATP-binding protein | ctg_00062 | |
| pstA | phosphate transport system permease protein | ctg_00063 | |
| pstC | phosphate transport system permease protein | ctg_00064 | |
| pstS | phosphate transport system substrate-binding protein | ctg_00065 | |
| Sulfur metabolism | ssuB | sulfonate transport system ATP-binding protein | ctg_00353 |
| ssuC | sulfonate transport system permease protein | ctg_00352 | |
| ssuD | alkanesulfonate monooxygenase | ctg_00351 | |
| ssuA | sulfonate transport system substrate-binding protein | ctg_00350 | |
| ssuE | FMN reductase | ctg_00349 | |
| cysA | sulfate transport system ATP-binding protein | ctg_00327 | |
| cysW | sulfate transport system permease protein | ctg_00326 | |
| cysU | sulfate transport system permease protein | ctg_00325 | |
| cysP | sulfate transport system substrate-binding protein | ctg_00324 | |
| cysI | sulfite reductase hemoprotein beta-component | ctg_02867 | |
| cysJ | sulfite reductase flavoprotein alpha-component | ctg_01699 | |
| Siderophore | tonB | TonB-dependent transporters | ctg_00044, ctg_00494 |
| exbB | biopolymer transport protein | ctg_03795 | |
| exbD | biopolymer transport protein | ctg_03794 | |
| fhuE | outer membrane receptor for ferric coprogen | ctg_03457, ctg_02420, ctg_02095, ctg_00748 | |
| entD | enterobactin synthetase component D | ctg_03886 | |
| bfd | bacterioferritin-associated ferredoxin | ctg_01441 | |
| bfr | bacterioferritin | ctg_01439, ctg_04538, ctg_00624 | |
| Plant Hormones | trpA | tryptophan synthase alpha chain | ctg_00189 |
| trpB | tryptophan synthase beta chain | ctg_00190 | |
| trpE | anthranilate synthase component I | ctg_04614 | |
| trpG | anthranilate synthase component II | ctg_04613 | |
| trpD | anthranilate phosphoribosyltransferase | ctg_04612 | |
| trpC | indole-3-glycerol phosphate synthase | ctg_04611 | |
| iaaM | tryptophan 2-monooxygenase | ctg_04661 | |
| amiE | amidase | ctg_02687, ctg_02400, ctg_03665 | |
| NahG | salicylate hydroxylase | ctg_02543 | |
| dcyD | 1-aminocyclopropane-1-carboxylate deaminase | ctg_03709, ctg_00163 |
Disclaimer/Publisher’s Note: The statements, opinions and data contained in all publications are solely those of the individual author(s) and contributor(s) and not of MDPI and/or the editor(s). MDPI and/or the editor(s) disclaim responsibility for any injury to people or property resulting from any ideas, methods, instructions or products referred to in the content. |
© 2023 by the authors. Licensee MDPI, Basel, Switzerland. This article is an open access article distributed under the terms and conditions of the Creative Commons Attribution (CC BY) license (https://creativecommons.org/licenses/by/4.0/).
Share and Cite
Deng, B.; Wu, L.; Xiao, H.; Cheng, Q. Characterization of Pseudomonas sp. En3, an Endophytic Bacterium from Poplar Leaf Endosphere with Plant Growth-Promoting Properties. Forests 2023, 14, 2203. https://doi.org/10.3390/f14112203
Deng B, Wu L, Xiao H, Cheng Q. Characterization of Pseudomonas sp. En3, an Endophytic Bacterium from Poplar Leaf Endosphere with Plant Growth-Promoting Properties. Forests. 2023; 14(11):2203. https://doi.org/10.3390/f14112203
Chicago/Turabian StyleDeng, Beiyan, Ling Wu, Hongju Xiao, and Qiang Cheng. 2023. "Characterization of Pseudomonas sp. En3, an Endophytic Bacterium from Poplar Leaf Endosphere with Plant Growth-Promoting Properties" Forests 14, no. 11: 2203. https://doi.org/10.3390/f14112203
APA StyleDeng, B., Wu, L., Xiao, H., & Cheng, Q. (2023). Characterization of Pseudomonas sp. En3, an Endophytic Bacterium from Poplar Leaf Endosphere with Plant Growth-Promoting Properties. Forests, 14(11), 2203. https://doi.org/10.3390/f14112203

